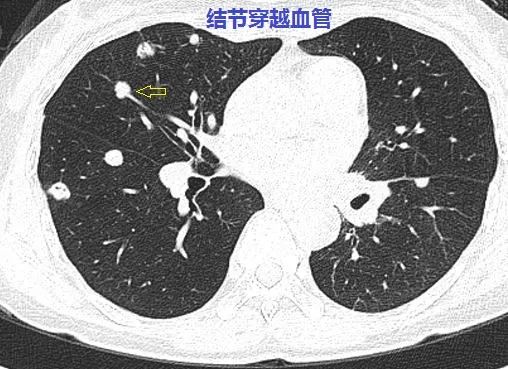
这个与血管相连的双肺多发小结节是怎样的神奇疾病

血管结节图片

【请教】皮下结节伴皮肤毛细血管扩张
图片尺寸3264x2448
结节性血管炎的患友们,你们是怎么坚持的? - 知乎
图片尺寸485x605
多发性皮肤上皮样血管瘤样结节病例分析
图片尺寸900x539
结节遍及双手臂,沿血管走形,未破溃.
图片尺寸2000x2667
皮肤性病科图谱: 皮肤血管炎 结节性血管炎
图片尺寸417x771
医生说我的肺结节有小血管,要不要手术切掉它?
图片尺寸1444x1600
2018acr结节性多动脉炎
图片尺寸960x720
多发性皮肤上皮样血管瘤样结节病例分析
图片尺寸900x539
"给疑难杂症病患带来福音"——我院血液风湿科成功诊治一名结节性多
图片尺寸600x809
这个与血管相连的双肺多发小结节是怎样的神奇疾病
图片尺寸510x372
变应性皮肤结节性血管炎
图片尺寸422x605
变应性皮肤结节性血管炎
图片尺寸421x569
毛刺征,空泡征,胸膜凹陷征及血管集束征,或者在随访观察过程中,有结节
图片尺寸643x483
以严重肠系膜血管炎为表现的结节性多动脉炎一例
图片尺寸621x428
爷爷得了结节性血管炎,症状一直在恶化,那能治好吗
图片尺寸512x509
这个与血管相连的双肺多发小结节是怎样的神奇疾病
图片尺寸477x364
这个与血管相连的双肺多发小结节是怎样的神奇疾病
图片尺寸508x369
临床实战_结节性多血管炎_医脉通
图片尺寸697x363
结节性血管炎双下肢红斑伴有皮肤破溃反复发病激素治疗可行吗
图片尺寸512x683
变应性皮肤结节性血管炎
图片尺寸300x160